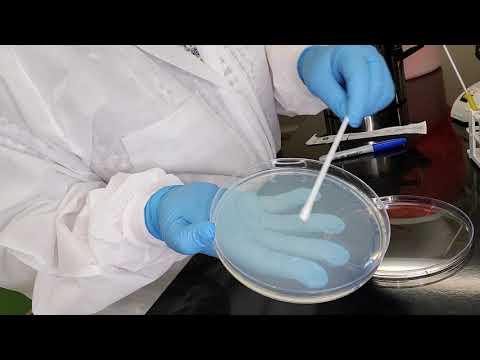

Loading song details...
The Kirby Bauer Method For Antibiotic Susceptibility With Examples
No description available.
MP3 Download
Video Download
Related Songs

6:30
Disc Diffusion Kirby Bauer Antimicrobial Susceptibility Testing

12:37
How To Do A Kirby Bauer Disk Diffusion Antimicrobial Susceptibility Test

9:41
The Kirby Bauer Method For Antibiotic Susceptibility With Examples

4:01
Kirby Bauer Disk Diffusion Method

3:06
Kirby Bauer Antibiotic Testing Method Microbiology

4:48
Kirby Bauer Assay Techniques Demonstration

1:00:54
Lab 7 3 Kirby Bauer Antibiotic Sensitivity Test

4:38
Testing An Antibiotic Using A Disk Diffusion Assay Kirby Bauer Method

9:20
Disk Diffusion Test Kirby Bauer

1:12
Kirby Bauer Test Time Lapse With E Coli And S Aureus

4:59
Kirby Bauer

3:23
How To Perform A Disk Diffusion Test Modified Kirby Bauer

6:21
Interpreting The Results Of Bauer Kirby Method Antibiotic Susceptibility Testing

2:55
MCB2010C Lab Kirby Bauer Method

4:45
Kirby Bauer Setup Iii21

2:48
Kirby Bauer Disc Diffusion Method For Antibiotic Susceptibility Testing

15:45
Antibiotic Sensitivity Lab Antibiotics Kirby Bauer Disk Diffusion MIC
9:37
Kirby Bauer Production

1:22
Kirby Bauer Technique

3:13